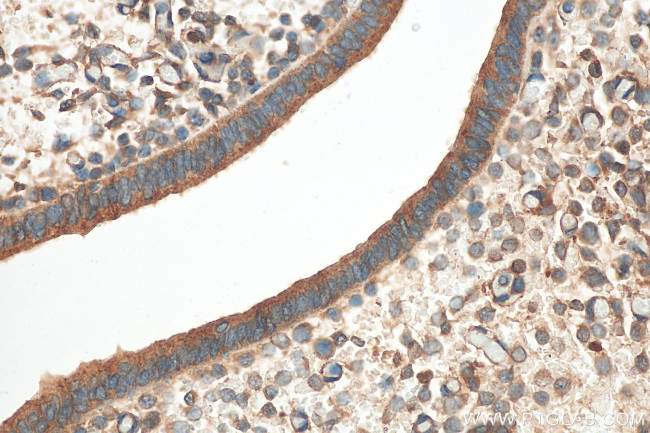
LCMT1 Antibody in Immunohistochemistry (Paraffin) (IHC (P))

Search
Proteintech
LCMT1 Polyclonal Antibody
{{$productOrderCtrl.translations['antibody.pdp.commerceCard.promotion.promotions']}}
{{$productOrderCtrl.translations['antibody.pdp.commerceCard.promotion.viewpromo']}}
{{$productOrderCtrl.translations['antibody.pdp.commerceCard.promotion.promocode']}}: {{promo.promoCode}} {{promo.promoTitle}} {{promo.promoDescription}}. {{$productOrderCtrl.translations['antibody.pdp.commerceCard.promotion.learnmore']}}
产品信息
30222-1-AP
种属反应
宿主/亚型
分类
类型
抗原
偶联物
形式
纯化类型
保存液
内含物
保存条件
运输条件
产品详细信息
Immunogen sequence: EEKLKKCNMN TQLPTLLIAE CVLVYMTPEQ SANLLKWAAN SFERAMFINY EQVNMGDRFG QIMIENLRRR QCDLAGVETC KSLESQKERL LSNGWETASA VDMMELYNRL PRAEVSRIES L
靶标信息
Perlecan is an extracellular matrix proteoglycan. It has a large core protein of 400-450 kDa and is often produced with heparan sulfate side chains. Perlecan is found in basement membranes where it contributes to the permeability characteristics, serves as a substrate for vascular cells and binds growth factors involved in vascular remodelling.
仅用于科研。不用于诊断过程。未经明确授权不得转售。
篇参考文献 (0)
生物信息学
蛋白别名: [Phosphatase 2A protein]-leucine-carboxy methyltransferase 1; Leucine carboxyl methyltransferase 1; protein methyltransferase; protein phosphatase methyltransferase 1; Protein-leucine O-methyltransferase; unnamed protein product
基因别名: AL033290; CGI-68; LCMT; LCMT-1; LCMT1; PPMT1
UniProt ID: (Human) Q9UIC8
Entrez Gene ID: (Human) 51451, (Mouse) 30949